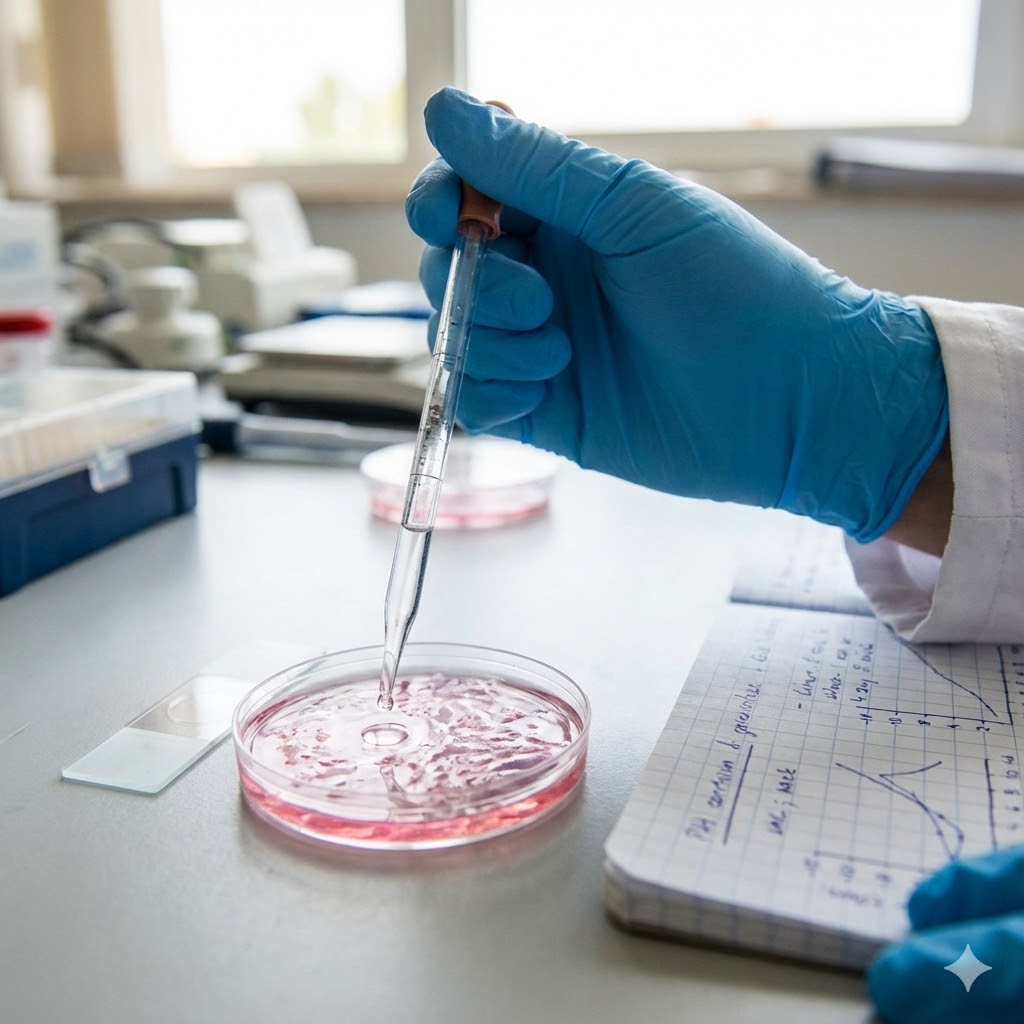
Plaquenil symboliseret ved en blåhandsket hånd der drypper væske i en petriskål med rosa indhold. Laboratorieomgivelser.

Plaquenil (hydroxychloroquin) og kræft
Indhold:
- Plaquenil (rul til)
- Parasitære midler sammenlignet (rul til)
Resumé om Plaquenil
Strategisk formål:
- At fungere som en metabolisk “blokade”, der forhindrer kræftceller i at reparere sig selv. Dette er afgørende i en metabolisk cocktail, da det forhindrer kræftcellerne i at overleve det stress, som andre repurposed drugs (f.eks. Metformin eller Ivermectin) påfører dem.
Metabolisk funktion:
- Plaquenil virker ved at ændre surhedsgraden i cellens lysosomer (fordøjelsessystem). Dette stopper “genbrugsstationen” (autofagi) og blokerer for optaget af næring fra omgivelserne, så cellen langsomt “kvæles” i sit eget affald.
Rolle i en protokol:
- Stoffet fungerer som en “force multiplier”. Det anvendes primært for at forstærke effekten af andre midler i forbindelse med kræftbehandling. Når andre stoffer presser kræftcellen, fjerner Plaquenil cellens evne til at modstå dette pres.
Hvad er Plaquenil

Plaquenil (hydroxychloroquin/HCQ) er kendt som et malariamiddel, men i den integrative kræftbehandling har det en helt anden og langt mere vital funktion. Her betragtes det som en metabolisk blokade.
Hvor kemoterapi og stråler forsøger at dræbe kræftcellen direkte ved at skade dens DNA, virker Plaquenil ved at sabotere cellens interne logistik og “fordøjelse”.
Det er en hjørnesten i flere selvbehandlings-protokoller (som f.eks. beskrevet i dele af FLCCC), fordi det angriber to fundamentale overlevelsesmekanismer, som aggressive kræftceller er dybt afhængige af for at modstå behandling, nemlig autofagi og macropinocytose (cellens indsugning af næring).
Indtagelse
Bør tages sammen med et måltid eller et glas mælk/ fedtholdig drik. Dette øger optagelsen og mindsker risikoen for mavegener.
Genbrugsstationen (autofagi)

Dette er den primære årsag til, at stoffet indgår i protokollerne, og det er her, slaget ofte skal slås for at undgå resistens.
Kræftceller har et ekstremt højt stofskifte. De producerer store mængder affald og beskadigede proteiner, især når de presses af kemoterapi eller stråling. For at overleve dette – og for at overleve i områder af tumoren med lav ilttilførsel – bruger de en proces kaldet autofagi (“selv-spisning”).
De nedbryder deres eget affald i cellens lysosomer (cellens fordøjelsessystem (surt miljø)) og genbruger det som ny energi. Det er deres ultimative overlevelses-kit.
Plaquenils virkning
Plaquenil er basisk og trænger ind i disse lysosomer. Her neutraliserer det syren. Uden et surt miljø virker de enzymer, der skal nedbryde affaldet, ikke.
- Konsekvens: Kræftcellens “skraldespand” bliver ikke tømt. Affaldet ophobes, og cellen kan ikke genvinde energi til reparation. Den “kvæles” langsomt indefra i toksisk affald og mister evnen til at reparere de skader, som anden behandling har påført den. [1, 3]
Dette er særligt effektivt mod kræftstamceller (CSC), som netop bruger autofagi til at gå i dvale og overleve standardbehandling, for senere at skabe tilbagefald eller metastaser.
Fødeindtaget (macropinocytose)

Mange aggressive kræftformer (især dem med KRAS-mutationer, som f.eks. bugspytkirtel- og tyktarmskræft) er afhængige af at “stjæle” proteiner fra deres omgivelser for at vokse. De gør det via en proces kaldet macropinocytose (“celle-drikning”), hvor de sluger store bidder af det omgivende væv.
Plaquenil blokerer denne proces effektivt. Når cellen har “slugt” proteinerne, skal de fordøjes i lysosomerne for at blive til brugbare aminosyrer. Fordi Plaquenil har ødelagt surhedsgraden i lysosomerne, kan cellen ikke fordøje maden. Den sulter reelt ihjel, selvom den er fuld af næring. [6]
Synergi med andre repurposed drugs

For brugere af protokoller (som Joe Tippens, Jane McLelland eller lignende) er det afgørende at forstå, hvordan Plaquenil spiller sammen med andre midler. Det skal ikke stå alene – det er en holdspiller, der gør de andre midler farligere for kræften.
Synergi med mTOR-hæmmere (f.eks. metformin)
Metformin og berberin hæmmer signalvejen mTOR (vækstsignalet). Når mTOR hæmmes, forsøger kræftcellen automatisk at aktivere autofagi for at overleve energimanglen. Hvis man tager metformin uden at blokere autofagi, giver man kræftcellen en flugtvej. Ved at tage Plaquenil sammen med metformin, lukker man flugtvejen. Metformin presser cellen på energien, og Plaquenil forhindrer den i at tilpasse sig presset. Det er et klassisk “hammer og ambolt”-princip.
Synergi med ivermectin/ fenbendazol
Mens parasitmidler som ivermectin og fenbendazol angriber cellens “skelet” (mikrotubuli) og energiproduktion, sørger Plaquenil for, at cellen ikke kan rydde op efter skaderne.
Desuden rammer disse midler alle kræftstamcellerne via forskellige mekanismer, hvilket øger chancen for total udryddelse af tumorvæksten. [5]
Synergi med statiner
Statiner hæmmer produktionen af kolesterol (nødvendigt for cellemembraner), hvilket stresser cellen. Plaquenil forhindrer cellen i at håndtere dette stress via autofagi.
Se også Repurposed drugs
Se også Parasittens vej til kræft
Immun-effekt og mikromiljø

Plaquenil gør mere end at stresse cellen indvendigt – det ændrer også slagmarken omkring cellen.
Dæmpning af inflammation
Plaquenil hæmmer Toll-like receptorer (immunforsvarets alarmsystem (TLR)). Mange tumorer skaber en kronisk inflammation omkring sig for at fremme vækst og holde kroppens dræberceller væk. Ved at dæmpe TLR-signalerne, fjerner man en del af denne “benzin” fra bålet og gør miljøet mindre gæstfrit for tumoren.
Normalisering af blodkar
Tumorer danner kaotiske, utætte blodkar for at skaffe blod hurtigt. Forskning tyder på, at Plaquenil (og klorokin) kan normalisere disse kar. For patienter, der modtager kemoterapi (selvom lægerne sjældent kombinerer det officielt i Danmark), betyder det, at medicinen bedre kan nå ind til tumorens kerne.
Det betyder også bedre iltning, hvilket gør strålebehandling markant mere effektiv, da stråler kræver ilt for at virke.
Særligt om bugspytkirtelkræft

Netop ved bugspytkirtelkræft (pancreascancer) spiller Plaquenil en særlig rolle i forskningen. Denne kræftform er ofte drevet af en mutation i KRAS-genet, som gør tumoren ekstremt afhængig af både autofagi og macropinocytose (opslugning af næring) for at overleve. Fordi kræftcellerne her lever i et meget iltfattigt og “arret” væv, har kemoterapi svært ved at virke alene.
Studier indikerer, at Plaquenil kan være nøglen til at bryde denne resistens, fordi det rammer præcis de to mekanismer, der holder KRAS-muterede celler i live. [6]
Hvorfor parasitmedicin virker mod kræft

Forbindelsen mellem parasitter og kræft er ikke tilfældig. At anvende antiparasitære midler som Plaquenil, Ivermectin eller Mebendazol mod kræft bygger på fundamentale biologiske ligheder mellem en parasit og en ondartet tumor. De deler en række overlevelsesstrategier, som gør dem sårbare over for samme type medicin.
1. Den metaboliske fællesnævner
Både parasitter og kræftceller adskiller sig fra normale celler ved deres ekstreme metaboliske behov. De skal vokse og dele sig eksplosivt i et miljø, der ofte er fjendtligt.
- Glukose-afhængighed: Begge typer celler udviser ofte det, der kaldes Warburg-effekten – en ineffektiv, men hurtig forbrænding af sukker (aerob glykolyse). Mange antiparasitære midler, herunder Plaquenil, griber ind i denne energiproduktion.
2. Signalveje og stamcelle-egenskaber
Kræftstamceller (CSC) er de celler i en tumor, der driver væksten og er ansvarlige for tilbagefald. Disse celler deler træk med parasitter ved at være “udødelige” og i stand til at gå i dvale for at undgå behandling.
- Både parasitter og kræftstamceller genbruger de kraftige ‘vækst-programmer’ (som f.eks. Wnt og Notch), som kroppen ellers kun bruger, når et foster skal dannes.
- Hvor traditionel kemoterapi ofte rammer celler i deling, rammer antiparasitære midler ofte disse signalveje, hvilket kan ramme selve “roden” til kræften. [10]
3. Immun-evasion (undvigelse af immunforsvaret)
En parasit kan kun overleve, hvis den kan snyde værtens immunforsvar til ikke at angribe. Kræftceller benytter samme taktik; de udsender signaler, der bremser immunforsvaret (immunsupression).
Genaktivering af kemoterapi

Resistens er en hovedudfordring i kræftbehandling. Kræftceller, der overlever første runde kemoterapi, gør det ofte ved at opregulere autofagi for at reparere skaderne på deres DNA.
Ved at kombinere kemoterapi med Plaquenil afskærer man denne flugtvej. Kemoen skader cellen, og Plaquenil forhindrer reparationen.
Dette koncept, kaldet chemosensitizing, er dokumenteret i flere studier, blandt andet inden for hoved-hals-kræft, hvor cisplatin-resistens blev overvundet [2].
Sikkerhed og bivirkninger

Plaquenil er et potent lægemiddel. For de, der selv sammensætter en protokol, er sikkerhed afgørende for ikke at skade kroppen midt i kampen.
Øjnene – den største risiko
Ved langtidsbrug kan stoffet ophobes i øjets pigmentceller og skade nethinden (retinopati). Det er sjældent, men alvorligt, da det kan give permanente synsskader.
- Krav: Bruger du Plaquenil i en fast protokol over flere måneder, skal du gå til øjenlæge mindst en gang om året (helst hver 6. måned ved høje doser).
Advarsel: Interaktion med kemoterapi
Der er en kendt, specifik kontraindikation mellem Plaquenil og kemopræparatet Etoposid.
Forskning viser, at de to stoffer ikke bør kombineres, da det kan hæmme kemoens virkning eller føre til uforudsigelig toksicitet. Desuden har Plaquenil i sjældne tilfælde sin egen dæmpende effekt på knoglemarven.
Er du i kemobehandling, der i forvejen presser dine blodplader og hvide blodlegemer i bund, kan tilføjelsen af Plaquenil være dråben, der får knoglemarven til at kollapse (agranulocytose).
Tal altid med onkologen om dine blodtal, før du blander Plaquenil med kemo.
Hjertet (QT-forlængelse)
Plaquenil kan påvirke hjerterytmen. Dette er især kritisk, hvis du kombinerer det med andre stoffer, der gør det samme. Vær især opmærksom på kombinationer med:
- Visse typer antibiotika (makrolider som azithromycin).
- Visse kvalmestillende midler (zofran/ ondansetron).
- Visse antidepressiva (SSRI). Tjek altid dine kombinationer i interaktionsdatabasen.
Mave-tarm
Kvalme og mavesmerter er almindeligt. Det hjælper ofte at tage tabletten sammen med et måltid, der indeholder fedt, da det mindsker irritationen af maveslimhinden.
Interaktioner (søg på præparater) (Interaktionsdatabasen, Lægemiddelstyrelsen) [8]
Forskning
Forskningen i Plaquenil som kræftmiddel bevæger sig fra prækliniske forsøg (celler og dyr) til kliniske studier på mennesker. Men det er desværre ikke en forskning der er økonomisk interesse i fra medicinalselskabers side, så det kniber med bevillinger til sådanne.
Kombinationseffekter
Et studie publiceret i 2025 har vist, at man ved at kombinere hydroxychloroquin med agonisten 2-BFI kan opnå en markant forstærket celledræbende effekt i tyktarmskræftceller.
Kombinationen øgede det oxidative stress i cellerne og førte til et kollaps i deres energistofskifte. Dette understreger pointen om, at Plaquenil sjældent skal stå alene, men fungerer bedst i synergi med andre stoffer. [1, 9]
Bugspytkirtelkræft
Særligt inden for bugspytkirtelkræft (pancreascancer) er der, som nævnt ovenfor, stor opmærksomhed på stoffet. Denne kræftform er notorisk svær at behandle og ekstremt afhængig af autofagi.
Flere studier undersøger, om tilføjelsen af Plaquenil til standardbehandling (som gemcitabine) kan forlænge overlevelsen ved at kvæle tumorernes energiforsyning [4].
Kliniske observationer
Der foreligger data, der indikerer, at patienter med autoimmune sygdomme, som er i langtidsbehandling med Plaquenil, i visse tilfælde har en ændret risiko-profil for kræft, hvilket har bidraget til hypotesen om en beskyttende eller terapeutisk effekt [3].
Konklusion

For den kræftramte, der søger veje uden om systemets standardtilbud – eller hvor standardtilbud er udtømt – repræsenterer Plaquenil en strategisk nødvendighed snarere end blot et “alternativ”.
Det er ikke en mirakelkur i sig selv. Men dets evne til at blokere kræftcellens mest potente overlevelsesmekanisme (autofagi) gør det til en “force multiplier”, der kan være forskellen på, om en behandling virker eller fejler.
Ved at fratage kræftcellerne muligheden for at reparere skader og tilpasse sig stress, tipper man balancen til fordel for patienten. Det er et værktøj, der kræver viden og respekt at bruge, men som tilbyder en reel, biokemisk begrundet mulighed for at genvinde kontrollen over sygdommen.
Interaktioner (søg på præparater) (Interaktionsdatabasen, Lægemiddelstyrelsen)
Se også Ivermectins immuntoksiske effekt
Se også Parasittens vej til kræft
Se også Repurposed Drugs
Se også Kræftbehandling baseret på den Mitochondrielle stamcelle-forbindelse
Se også Ingen medicin – Plan B
Fortsættes...
Links
[1] Hydroxychloroquine: Key therapeutic advances and clinical applications (ScienceDirect, 2023)
- Indhold: En dybdegående videnskabelig gennemgang fra 2023. Artiklen beskriver detaljeret, hvordan HCQ hæver pH i lysosomerne og dermed blokerer for autofagi. Den konkluderer, at stoffet er lovende både som monoterapi og især i kombination med andre behandlinger.
[2] Malaria drug could combat chemotherapy-resistant head and neck cancers (ecancer, 2022)
- Indhold: En artikel om et studie fra University of Pittsburgh, der viser, at hydroxychloroquine kan overvinde resistens over for kemidlet cisplatin. Artiklen forklarer, hvordan kræftceller bruger autofagi til at undvige kemo, og hvordan HCQ blokerer denne flugtvej.
[3] Repurposing Drugs in Oncology (ReDO)—Chloroquine and hydroxychloroquine as anti-cancer agents (Ecancer, Medical Science, 2017)
- Indhold: Hovedværket fra ReDO-projektet. En komplet og ekstremt grundig gennemgang, der samler al evidens for brug af klorokin og hydroxychloroquin mod en lang række kræftformer. Uundværlig for den, der vil dykke helt ned i data.
[4] Autophagy inhibitors for cancer therapy: Small molecules targeting autophagy (ScienceDirect, 2023)
- Indhold: En teknisk artikel, der forklarer biologien bag resistens. Den understreger, at uden en autofagi-hæmmer (som Plaquenil) vil mange behandlinger miste deres effekt over tid, fordi kræften lærer at reparere sig selv.
[5] Ivermectin, a potential anticancer drug derived from an antiparasitic agent (Science Direct, 2021)
- Indhold: Relevant for cocktail-tilgangen. Beskriver ivermectins mekanismer, hvilket gør det muligt at se synergien med Plaquenils oprydnings-blokade.
[6] Evidence-based complementary treatment of pancreatic cancer (Dove Medical Press, 2018)
- Indhold: En gennemgang af supplerende behandlinger til bugspytkirtelkræft, herunder hydroxychloroquin. Artiklen er central, fordi den specifikt adresserer brugen af HCQ til at ramme denne kræftforms særlige metaboliske afhængighed (autofagi/macropinocytose), som gør den svær at behandle konventionelt.
[7] The imidazoline I2 receptor agonist 2-BFI enhances cytotoxic activity of hydroxychloroquine (PubMed, 2025)
- Indhold: Et studie, der viser fremtiden for kombinationsbehandlinger. Det dokumenterer, hvordan man kan forstærke HCQ’s effekt ved at stresse cellen yderligere (oxidativt stress) og få energistofskiftet til at kollapse i kræftceller.
[8] Hydroxychloroquine (Drugs.com, 2024)
- Indhold: Detaljeret information om bivirkninger, doseringer og kontraindikationer. Vigtig for sikkerhedstjek.
[9] Phase I trial of hydroxychloroquine to enhance palbociclib (Nature, 2025)
- Indhold: Et klinisk studie, der undersøger effekten af at kombinere hydroxychloroquin med kræftmedicinen palbociclib. Forskningen indikerer, at kombinationen kan forstærke virkningen mod brystkræftceller, hvilket potentielt kan mindske behovet for høje doser og dermed reducere bivirkninger.
[10] Targeting the Mitochondrial-Stem Cell Connection in Cancer Treatment: A Hybrid Orthomolecular Protocol (Journal of Orthomolecular Medicine, 2024)
- Indhold: Artiklen introducerer en “hybrid protokol”, der kombinerer repurposed drugs (som doxycyklin) og kosttilskud. Formålet er specifikt at ramme kræftstamceller ved at afskære deres energiforsyning i mitokondrierne, hvilket underbygger den metaboliske tilgang, hvor Plaquenil også indgår.
Siden oprettet:
d. 01.07.24. Senest revideret d. 12.12.25
Fortsættes…
❤
Hvad du læser på Jeg har Kræft er ikke en anbefaling. Søg kompetent vejledning.
Parasitære lægemidler – sammenligning
Kort resumé om forskelle og ligheder
Selvom flere midler mod parasitter undersøges for deres effekt mod kræft, virker de på vidt forskellige måder:
Mebendazol:
- Ødelægger kræftcellens indre “skelet” (mikrotubuli) for at stoppe celledeling. Er det, af de her nævnte stoffer, der er mest undersøgt i kliniske forsøg.
Fenbendazol:
- Ødelægger også cellens “skelet”, men menes derudover at skabe metabolisk stress. Har en stærk anekdotisk historik.
Niclosamid:
- Afbryder cellens energiforsyning og blokerer samtidig dens vækstsignaler.
Ivermectin:
- Skaber internt stress i cellen og forhindrer den i at pumpe kemoterapi ud, hvilket kan modvirke resistens.
Hydroxychloroquin:
- Blokerer cellens “genbrugssystem” (autofagi), så den bukker under for sit eget affald.
Pointen er, at de forskellige mekanismer åbner for strategiske kombinationer, hvor kræften kan angribes fra flere vinkler samtidigt for at opnå en stærkere effekt.
Parasitmidler sammenlignet

Et af de mest lovende områder inden for komplementær og eksperimentel kræftbehandling er genanvendte lægemidler – eller repurposed drugs. En særligt interessant gruppe er midlerne mod parasitter.
Mange af disse stoffer har vist sig at have potente kræfthæmmende egenskaber, men det er afgørende at forstå, at de ikke alle virker på samme måde. Deres angreb på kræftceller er vidt forskellige.
Nedenfor følger en sammenligning af de mest omtalte stoffer og deres unikke virkningsmekanismer for at give et klart overblik over deres individuelle styrker og potentiale.
Mebendazol (Vermox)

- Hovedmekanisme: Destruktion af mikrotubuli (cellens stillads) Mebendazols primære og mest veldokumenterede virkning er en forstyrrelse af kræftcellernes indre skelet. Stoffet, der tilhører benzimidazol-familien, virker ved at binde sig til proteinet tubulin og forhindre det i at samle sig til mikrotubuli. Dette standser effektivt celledelingen (mitosen) og fører til celledød.
Mebendazol er desuden det benzimidazol, der har været genstand for flest formelle kliniske undersøgelser, især i forbindelse med aggressive hjernetumorer (glioblastom), hvor det er blevet testet som et supplement til standard kemoterapi. - Kendetegn: Et direkte, fysisk angreb på cellens struktur. Er det benzimidazol, der er mest undersøgt i kliniske forsøg på mennesker.
Se også links nederst på siden
Fenbendazol

- Hovedmekanisme: Destruktion af mikrotubuli (cellens stillads) Fenbendazol deler den samme kernemekanisme som mebendazol, nemlig at ødelægge kræftcellernes mikrotubuli og dermed stoppe celledeling. Dets popularitet er dog i højere grad drevet af prækliniske studier (laboratorie- og dyreforsøg) samt stærke patientberetninger og overbevisende anekdotisk evidens.
- Sekundære mekanismer: Udover mikrotubuli-effekten peger forskning på, at fenbendazol har en særlig evne til at stresse kræftcellernes stofskifte ved at blokere for deres sukkeroptag. Visse studier indikerer også, at det kan reaktivere det kræftundertrykkende gen p53.
- Kendetegn: Det er således kendetegnet ved at have en stærk anekdotisk historik og et fokus i forskningen på dets evne til at skabe metabolisk stress.
Se også links nederst på siden
Niclosamid

Niclosamid har en helt anden tilgang, der primært er metabolisk og signal-orienteret.
- Hovedmekanisme: Metabolisk kollaps (energi-blokade) Niclosamid virker som en “afkobler” i kræftcellens kraftværker, mitokondrierne. Den kortslutter simpelthen den proces, der producerer energi (ATP), hvilket fører til et øjeblikkeligt og fatalt energitab i cellen. Samtidig skabes et massivt oxidativt stress (via ROS-produktion), der yderligere skader cellen.
- Sekundær, men afgørende mekanisme: Signal-sabotage Udover energi-blokaden er niclosamids store styrke dets evne til simultant at hæmme en lang række centrale signalveje, som kræftceller er afhængige af (Wnt, STAT3, mTOR, NF-κB). Dette rammer ikke kun væksten, men også de ellers modstandsdygtige kræftstamceller.
- Kendetegn: Et dobbeltangreb, der både fjerner cellens brændstof og afbryder dens interne kommunikation.
Se også links nederst på siden
Ivermectin

Ivermectin er igen anderledes end de ovenfor nævnte, og virker bredt på flere systemer, der har med cellestress og transport at gøre.
- Hovedmekanisme: Induktion af oxidativt stress og ion-ubalance Ligesom niclosamid kan ivermectin skabe et højt niveau af oxidativt stress (ROS), der er giftigt for kræftcellen. Det menes også at påvirke ionkanaler i cellemembranen, hvilket forstyrrer den skrøbelige elektriske balance, cellen opretholder.
- Sekundær, men afgørende mekanisme: Hæmning af transportpumper En af hovedårsagerne til kemoresistens er, at kræftceller udvikler pumper (som P-glykoprotein), der aktivt skubber kemoterapi ud af cellen igen. Ivermectin har vist sig at kunne blokere disse pumper. Det betyder, at det kan gøre resistente kræftceller følsomme over for kemoterapi igen, da giften nu bliver inde i cellen.
- Kendetegn: Skaber internt stress og forhindrer kræftcellen i at “pumpe” giftstoffer ud.
Se også links nederst på siden
Hydroxychloroquin (Plaquenil)

Dette stof, som er et malariamiddel, har en meget specifik og unik mekanisme.
- Hovedmekanisme: Blokering af autofagi (cellens genbrugsstation) Autofagi er en overlevelsesmekanisme, hvor cellen nedbryder og genbruger sine egne beskadigede dele for at skaffe energi og byggesten under pres (f.eks. under kemoterapi). Hydroxychloroquin blokerer denne proces. Resultatet er, at kræftcellen ikke kan “rydde op” i sig selv, og der ophobes giftigt affald inde i den. Dette gør cellen markant mere sårbar og kan skubbe den mod celledød, især når den i forvejen er stresset af anden behandling.
- Kendetegn: Forhindrer kræftcellen i at “spise sig selv” for at overleve pres.
Se også links nederst på siden
Artemisinin (og derivater)

- Hovedmekanisme: Jern-aktiveret celledød via frie radikaler Artemisinin, der oprindeligt er et Nobelpris-vindende lægemiddel mod malaria, har en yderst effektiv og specifik virkningsmekanisme. Kræftceller har brug for store mængder jern for at kunne dele sig hurtigt, og de har derfor en meget højere koncentration af jern end normale, sunde celler.
Artemisinin-molekylet indeholder en særlig kemisk struktur (en endoperoxid-bro), der reagerer voldsomt, når den kommer i kontakt med jern. Denne reaktion skaber en eksplosion af ustabile og meget skadelige molekyler kaldet frie radikaler (specifikt Reactive Oxygen Species, ROS). Denne interne “bombe” af oxidativt stress ødelægger kræftcellens membraner, proteiner og DNA indefra og tvinger den i celledød. Processen har ligheder med en specifik type celledød kaldet ferroptose (jern-afhængig celledød). - Adgang i Danmark: Det rene, mest potente stof artesunat (et derivat) er et receptpligtigt lægemiddel i Danmark, mens planten Artemisia annua typisk kan købes som kosttilskud.
- Kendetegn: Fungerer som en “trojansk hest”, der udnytter kræftcellens egen jern-afhængighed til at skabe en målrettet, intern eksplosion.
Se også links nederst på siden
Resistens og sikkerhed ved langtidsbrug
Når man anvender parasitære lægemidler i en onkologisk sammenhæng, er der kritiske faktorer vedrørende resistens og sikkerhed, der gør sig gældende for alle præparaterne.
Risiko for klinisk resistens
- Kræftceller er biologisk ekstremt tilpasningsdygtige. Selvom enkelte kliniske observationer kan antyde mangel på resistens, dokumenterer omfattende forskning, at kræftceller over tid kan udvikle modstandsdygtighed. Den mest centrale mekanisme er overekspression af såkaldte ABC-transportere (herunder P-glykoprotein). Disse fungerer som molekylære pumper, der aktivt fjerner medicinen fra cellens indre, før den når at virke [1, 4]. Vedvarende eksponering uden pauser kan skabe et selektionspres, hvor kun de mest modstandsdygtige kræftceller overlever og opformeres [2].
Betydningen af monitorering
- Da behandling af kræft ofte kræver højere doser eller længere tidsforbrug end en standard parasitkur, er løbende overvågning afgørende. Dette gælder især for benzimidazoler (som mebendazol), hvor langvarig brug er forbundet med risiko for medicin-induceret levertoksicitet [3]. Monitorering med blodprøver, herunder levertal (ALAT/ASAT), er derfor en nødvendig sikkerhedsforanstaltning for at sikre, at behandlingen kan fortsætte uden at skade organerne.
Oversigt

| Lægemiddel | Primær Virkningsmekanisme | Særlige Kendetegn |
| Mebendazol | Destruktion af mikrotubuli | Angriber cellens “skelet”. Mest undersøgte i kliniske forsøg. |
| Fenbendazol | Destruktion af mikrotubuli | Angriber cellens “skelet”. Stærk anekdotisk historik. |
| Niclosamid | Metabolisk kollaps (energi-blokade) | Fjerner cellens brændstof og saboterer signalveje. Vanskeligt optageligt. |
| Ivermectin | Induktion af oxidativt stress / Hæmning af pumper | Skaber internt stress og modvirker kemoresistens. |
| Hydroxychloroquin | Hæmning af autofagi | Forhindrer cellens “genbrugssystem” i at virke. |
| Artemisinin (og derivater) | Jern-aktiveret dannelse af frie radikaler (ROS) | Udnytter kræftcellers høje jernindhold til at skabe oxidativt stress. |
Konklusion

Den klare konklusion er, at der ikke findes én “antiparasitær” virkning mod kræft. Hvert stof repræsenterer en unik angrebsvinkel, der udnytter forskellige sårbarheder i kræftcellens komplekse maskineri.
Denne diversitet åbner for intelligente kombinationsbehandlinger, hvor man kan ramme en tumor fra flere sider samtidigt. På sigt kan en dybere forståelse af disse mekanismer føre til mere skræddersyet behandling, hvor valget af et repurposed drug baseres på den enkelte tumors specifikke biokemiske profil.
Potentialet ligger således ikke i et enkelt “vidundermiddel”, men i den strategiske brug af et helt arsenal af forskellige, genfundne “nøgler”, der hver især kan låse en ny dør op i kræftcellens forsvar.
Der er ovenfor tale om lægemidler, hvorfor det selvsagt er naturligt at diskutere brugen af sådanne med sin behandler.
Se også Metabolisk strategi – bloker signalveje efter kræfttype – skema-oversigter
Hvis du er i tvivl om interaktion, kan det tjekkes her:
Se også Repurposed Drugs
Se også Ingen medicin – Plan B
Se også Parasittens vej til kræft
Links
Ivermectin:
Ivermectin, a potential anticancer drug derived from an antiparasitic agent (Science Direct, 2021)
- Relevans: Denne artikel giver en bred oversigt over de mange foreslåede anti-kræft mekanismer for ivermectin. Den nævner bl.a. effekten på Hippo-, Akt/mTOR- og WNT-signalvejene, hvilket underbygger stoffets alsidighed.
The river blindness drug Ivermectin and related macrocyclic lactones inhibit WNT-TCF pathway responses in human cancer (EMBO Molecular Medicine, 2014)
- Relevans: Et meget specifikt studie, der bekræfter, at ivermectin er en effektiv blokker af WNT-signalvejen, som er en fundamental og ofte overaktiv signalvej i mange kræftformer, herunder tarm- og brystkræft.
- Relevans: Et nyt dyrestudie viser, at lægemidlet ivermectin har en stærk anti-kræft effekt på ikke-småcellet lungekræft (NSCLC). Studiet konkluderer, at ivermectin virker ved at blokere den centrale vækst-signalvej (EGFR/PI3K/AKT/mTOR), hvilket fører til øget celledød og hæmmet tumorvækst.
Ivermectin and Cancer: Exploring the Potential Link (Williams Cancer Institute, 2023)
- Relevans: Ivermectin har potential som kræftbehandling ved at hæmme tumorvækst, inducere apoptose, styrke immunforsvaret og forhindre angiogenese. Disse mekanismer kan supplere eksisterende terapier, men yderligere klinisk forskning er nødvendig. Samlet set åbner Ivermectin nye muligheder for udvikling af innovative kræftbehandlinger.
Ivermectin, a potential anticancer drug derived from an antiparasitic drug (Science Direct, 2021)
- Relevans: Ivermectin, an antiparasitisk macrolid, har vist lovende potential som kræftbehandling ved at hæmme tumorcelleproliferation og fremme apoptosis gennem flere signalveje. Dette åbner muligheder for klinisk anvendelse af ivermectin som en anti-neoplastisk agent. Yderligere forskning er nødvendig for at realisere dette potentiale i kræftbehandling.
Fenbendazole:
Fenbendazole, Ivermectin and Mebendazole for Breast Cancer Success Stories – 37 Case Reports (The Medical Adviser, June 2025)
- Relevans: Flere peer-reviewed artikler og case-studier antyder, at Fenbendazol, Ivermectin og Mebendazol muligvis kan spille en vigtig rolle i behandlingen af stadium 4 brystkræft. Forskning viser, at disse stoffer har forskellige anti-cancer mekanismer, der kan være effektive mod kræftceller. Specifikke studier inkluderer en protokol for Ivermectin, samt undersøgelser af Fenbendazole og Mebendazole i relation til brystkræft og metastaser.
- Relevans: Fenbendazol kan både dræbe almindelige kræftceller og de svære cancer-stamceller i livmoderhalskræft ved at forstyrre cellernes vækstcyklus. Det stoppede tumorvækst i dyremodeller uden vægttab, i modsætning til kemoterapi, og gav fuld overlevelse hos de behandlede. Disse resultater gør fenbendazol til et lovende behandlingsvalg mod livmoderhalskræft.
Transcriptome analysis reveals the anticancer effects of fenbendazole on ovarian cancer: an in vitro and in vivo study (PubMed, 2024)
- Relevans: Fenbendazol kan hæmme væksten og fremme døden af ovariecancerceller ved at forstyrre cellecyklus og forårsage mitotisk katastrofe. Det viste sig også at reducere tumorvækst i mus, hvilket tyder på, at det kan blive en lovende behandling for ovariecancer. Disse resultater åbner muligheder for nye terapier mod denne alvorlige sygdom.
Mebendazole:
Albendazole and Mebendazole as Anti-Parasitic and Anti-Cancer Agents: an Update (PubMed, 2021)
- Relevans: Albendazole og mebendazole er bredspektrede ormekurmedicin, der blokerer mikrotubuli og har vist lovende anti-cancer effekter in vitro og in vivo. De kan bruges mod parasitære infektioner og potentielt som kræftbehandling, men langvarig brug kan forårsage bivirkninger som leverskade. Mebendazole er i øjeblikket mere populært i kræftforsøg på grund af albendazoes toksicitet.
- Relevans: Mebendazol og paclitaxel har synergisk effekt på at hæmme proliferation og microtubulære strukturer i oral tongue squamous cell carcinoma (OTSCC) ved at inhibere PI3K/AKT-signaleringsvejen. Kombinationen øger apoptose-markører og kan være en lovende behandling for OTSCC. Yderligere forskning er nødvendig for at bekræfte deres kliniske potentiale.
In vitro evaluation of lipidic nanocarriers for mebendazole delivery to improve anticancer activity (PubMed, 2024)
- Relevans: Mebendazol-nanostrukturer (MBZ-NLCs) er stabile og indeholder en større del af det aktive stof end almindelige former. De er ti gange mere effektive mod kræftceller og kan forhindre kræftcellers bevægelse i laboratorieforsøg. Resultaterne tyder på, at mebendazol-nanostrukturer kan blive en god behandling for lungekræft, men der er behov for flere tests i kroppen.
Plaquenil:
- Relevans: Et nyt studie viser, at stoffet 2-BFI (en imidazoline I2-receptor agonist) markant forstærker den celledræbende effekt af autofagi-hæmmeren hydroxychloroquin (HCQ) mod tarmkræftceller. Kombinationen virker ved at skabe øget oxidativt stress og forstyrre kræftcellernes stofskifte og overlevelsesmekanismer.
Malaria Drug Could Combat Chemotherapy-Resistant Head and Neck Cancers (UPMC, 2022)
- Relevans: Dette er en letforståelig opsummering af et studie, der viser et helt konkret eksempel på, hvordan hydroxychloroquin bruges til at overvinde kemo-resistens. Det forklarer, hvordan stoffet kan “gen-sensibilisere” kræftceller, så kemoterapien virker igen.
Repurposing Drugs in Oncology (ReDO)—chloroquine and hydroxychloroquine as anti-cancer agents (PubMed, 2017)
- Relevans: Chloroquine (CQ) og hydroxychloroquine (HCQ) har potential som anti-cancer behandling, især i kombination med standardterapier. De påvirker både cancer celler og tumor-mikromiljøet gennem autophagihæmning og modulation af signalveje som p53 og CXCR4-CXCL12. Yderligere kliniske studier er nødvendige for at optimere dosering og behandlingsregimer.
Niclosamide:
- Relevans: Denne undersøgelse identificerede 35 gener, inklusive CDK1 og TTK, som vigtige mål i ovarian cancer, der ofte udvikler resistens mod behandling. NSC765690 (MCC22) blev fundet som en lovende niclosamide-analog med stærk aktivitet mod begge mål, hvilket kan hjælpe med at overvinde kemoterapiresistens. Resultaterne viser en datadrevet tilgang til at udvikle nye terapier mod ovarian cancer.
Niclosamide Treatment Suppressed Metastatic, Apoptotic, and Proliferative Characteristics of MDA-MB-231 Cancer Stem Cells (PubMed, 2025)
- Relevans: Dette studie viste, at niclosamide effektivt inducerer apoptosis og stopper cellecyklussen i aggressive triple-negativ brystkræft-CSCs i en 3D-model. Behandlingen reducerede metastase- og resistensrelaterede gener samt EMT-markører, hvilket kan forbedre behandlingseffektiviteten mod cancer. Resultaterne tyder på, at niclosamide kan øge CSCs følsomhed og forebygge tumorrecidiv.
Pharmacological advances and therapeutic applications of niclosamide in cancer and other diseases (PubMed, 2025)
- Relevans: Niclosamide er et FDA-godkendt lægemiddel med potentiale i cancerbehandling, især mod resistent ovarian cancer, ved at modulere celleproliferation og apoptose. Nye formuleringer og nanoteknologi forbedrer bioavailability, hvilket styrker dets terapeutiske muligheder. Det viser lovende alsidighed i behandling af cancer, viral infektion og inflammatoriske sygdomme.
- Relevans: NHC, en forbedret form af niclosamide, viser øget solubilitet og potentiale som behandling for colon cancer. Analysen bekræfter, at NHC er effektivere end NES, og metabolomics samt 16S rRNA undersøger dets mekanisme. Dette kan åbne nye muligheder for niclosamide-baseret cancerbehandling.
Antitumor activity of niclosamide-mediated oxidative stress against acute lymphoblastic leukemia (PubMed, 2024)
- Relevans: Niclosamide viste sig at kunne hæmme væksten og fremkalde apoptosis i akut lymfoblastisk leukæmi (ALL) ved at øge reaktive iltarter og aktivere TP53. Det har potentiale som en ny behandling for at forbedre responsen og forlænge overlevelsen hos ALL-patienter. Disse resultater indikerer, at niclosamide kan blive et lovende terapeutisk middel mod ALL.
Alment:
Targeting the Mitochondrial-Stem Cell Connection in Cancer Treatment: A Hybrid Orthomolecular Protocol (Journal of Orthomolecular Medicine)
Interaktioner (søg på præparater) (Interaktionsdatabasen, Lægemiddelstyrelsen)
Resistens og monitorering
[1] The emerging roles of ATP-binding cassette transporters in cancer multidrug resistance (ScienceDirect, 2025)
- Indhold: En helt opdateret gennemgang af, hvordan ABC-transportere fungerer som pumper, der skaber resistens i kræftceller. Artiklen beskriver udfordringerne ved at overvinde denne mekanisme for at sikre effektiv medicinlevering.
[2] Repurposing Drugs in Oncology (ReDO)—A project to find new uses for old drugs (ecancer, 2014)
- Indhold: En omfattende artikelserie, der gennemgår behovet for monitorering og de teoretiske risici for resistens, når man flytter medicin fra kortvarig brug til langvarig kræftbehandling.
[3] Albendazole and Mebendazole as Anti-Parasitic and Anti-Cancer Agents: an Update (PubMed, 2021)
- ndhold: En artikel på baggrund af en gennemgang af benzimidazoler (mebendazol og albendazol). Den beskriver deres anti-kræft effekter, men fastslår direkte, at langvarig brug kan forårsage bivirkninger som leverskade.
[4] Revisiting the role of ABC transporters in multidrug-resistant cancer (PubMed, 2018)
- Indhold: En videnskabelig artikel, der dokumenterer, hvordan kræftcellers overudtryk af ABC-transportere (især P-glykoprotein) er en hovedårsag til, at kræften bliver modstandsdygtig (resistent) over for behandling. Artiklen påviser, at disse pumper effektivt fjerner medicin fra cellerne og dermed blokerer for effekten.
Siden oprettet:
d. 01.07.24, Senest revideret d. 02.07.25
❤
Hvad du læser på Jeg har Kræft er ikke en anbefaling. Søg kompetent vejledning.
Forfatterinfo og professionelt grundlag

Samtlige artikler på dette site er udarbejdet og valideret af undertegnede, Hanne Kjær Uhlig. Jeg er uddannet sygeplejerske (1975, med klinisk erfaring frem til 2013) og cand.arch. (1983, med speciale i industriel design), samt underviser i en årrække på DTU (Danmarks Tekniske Universitet).
Efter tabet af min mor til kræft i 2000 og min egen kræftdiagnose i 2024, stiftede jeg dette non-profit informationssite Jeg har Kræft.
Målet er at bruge min analytiske og akademiske systematik til at bringe overblik, sikkerhed og videnskabelig dokumentation ind i feltet for integrativ, komplementær og alternativ kræftbehandling. Samtidig benyttes min sundhedsfaglige erfaring til at gøre artikler patientnære – og vedkommende.
Artiklens kendetegn:
- Klinisk og personlig ballast: Skabt ud fra en kombination af årtiers erfaring som sygeplejerske og egne oplevelser som patient og pårørende.
- Videnskabelig systematik: Indholdet bygger på systematisk research af medicinske databaser samt kliniske forsøg. Artiklerne er konsekvent underbygget med kildehenvisninger under Links.
- Uafhængigt non-profit projekt: Driften sikres via frivillige bidrag og medlemskaber gennem Støtteforeningen Jeg har Kræft. Sitet er fuldstændig uafhængigt af kommercielle producentinteresser og arbejder udelukkende for at fremme kræftramtes livskvalitet.
- Støtteforeningens bestyrelse består af:
- Formand: Hanne Kjær Uhlig , sygeplejerske og cand.arch.
- Kasserer: Jens Ottosen-Støtt, jurist
- Medlem: Thomas Kjær Uhlig, speciallæge, øjensygdomme
- Medlem: Martin Kjær Uhlig, cand.merc.aud.
Fællesskab: Bliv medlem af Facebookgruppen: Jeg har Kræft – Hvad kan jeg gøre?
❤
Hvad du læser på Jeg har Kræft er ikke en anbefaling. Søg kompetent vejledning.

